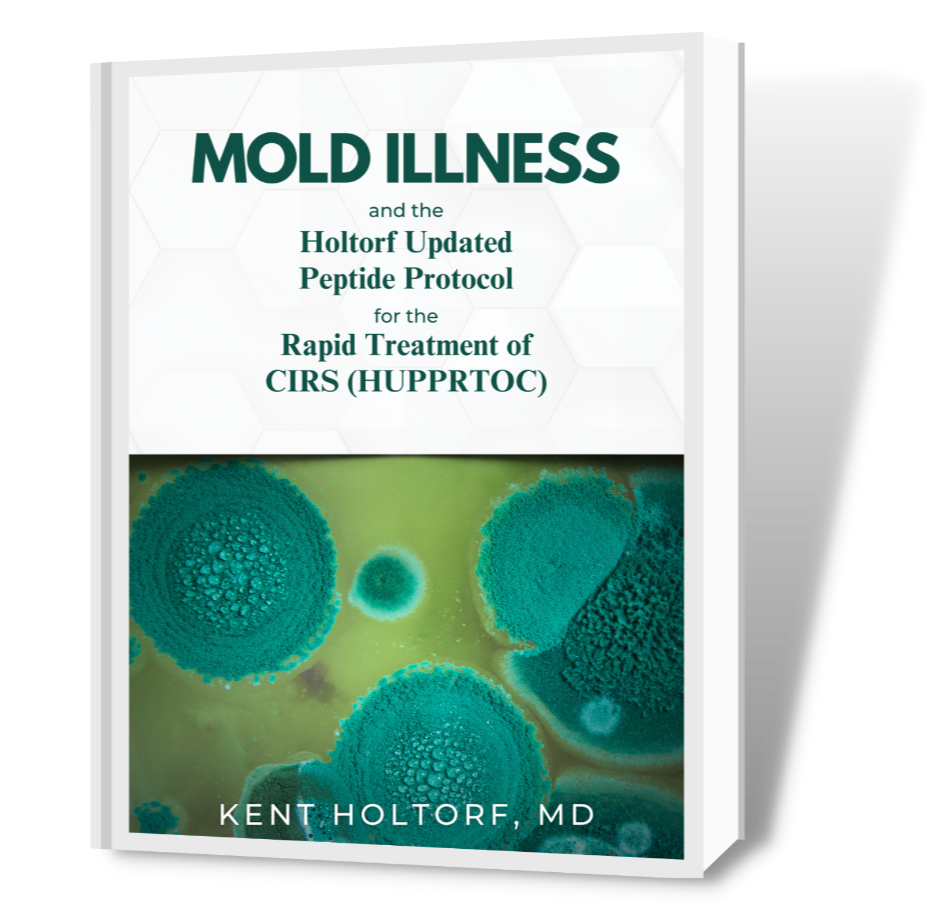

Books to Improve your overall health.
Cracking The STEM Cell Code
Christian Drapeau, MSC
Stem cell scientist and creator of STEMREGEN explores the scientific and historical foundations of stem cells, unveiling the remarkable story of the body's natural repair system.
Mind to Matter
Dawson Church
From a symphony to a marriage to an ice cream cone to a rocket launch, every creation begins as a thought. When we have an intention, a complex chain of events begins in our brains.
Mold Illness
Dr. Kent Holtorf
His expertise is vast, encompassing areas such as tick-borne illnesses, chronic fatigue syndrome,
fibromyalgia, CIRS, MCAS, long-COVID, TBI, PTSD, neurodegenerative diseases, complex
multisystem illness, and beyond
Becoming Supernatural

Dr. Joe Dispenza
The author of the New York Times bestseller You Are the Placebo, as well as Breaking the Habit of Being Yourself and Evolve Your Brain, draws on research conducted at his advanced workshops since 2012 to explore how common people are doing the uncommon to transform themselves and their lives.
Missing Microbes

Dr. Martin Blaser
A critically important and startling look at the harmful effects of overusing antibiotics, from the field’s leading expert
Tracing one scientist’s journey toward understanding the crucial importance of the microbiome, this revolutionary book will take readers to the forefront of trail-blazing research while revealing the damage that overuse of antibiotics.
Science Set Free

Dr. Rupert Sheldrake
In Science Set Free (originally published to acclaim in the UK as The Science Delusion), Dr. Rupert Sheldrake, one of the world’s most innovative scientists, shows how assumptions are constricting science has, over the years, hardened into dogmas. Such dogmas are not only limiting but dangerous for the future of humanity.
The End Of Alzheimer’s

Dr. Dale Bredesen
The instant New York Times and Wall Street Journal bestseller
A groundbreaking plan to prevent and reverse Alzheimer’s Disease that fundamentally changes how we understand cognitive decline.
Brain Maker

Dr. David Perlmutter
Grain Brain's bestselling author uncovers the powerful role of gut bacteria in determining your brain’s destiny. Debilitating brain disorders are on the rise-from children diagnosed with autism and ADHD to adults developing dementia at younger ages than ever before.
Power, Sex, Suicide

Nick Lane
Mitochondria are tiny structures located inside our cells that carry out the essential task of producing energy for the cell. They are found in all complex living things, and in that sense, they are fundamental for driving complex life on the planet.
What the Health
Kip Andersen
The Health and the award-winning Cowspiracy documentaries take readers on a science-based tour of the hazards posed by consuming animal products—and what happens when we stop.
Eat to Live
Dr. Joel Fuhrman
Dr. Fuhrman's discovery of toxic hunger and the role of food addiction in weight issues. It instructs readers on how to leave behind the discomfort of toxic hunger, cravings, and addictions to unhealthy foods.
The Melatonin Miracle
Walter Pierpaoli
The discovery of our body's aging clock and melatonin's role as its regulator is a revolutionary medical breakthrough - one that can give you the power to reverse the effects of aging.
Total Gut Balance
Dr. Ghannoum
A groundbreaking guide to your gut
Most people understand the importance of a healthy gut microbiome for digestive health and overall wellbeing.
Cancer Proof
Dr. Heather Paulson
Did you know that cancer-proofing your life can be easy and practical? This book will cover the seven areas of your health that need to be addressed to live cancer-free.
The Methuselah Factor

Dr. David Derose
"The Methuselah Factor" provides practical, life-changing insights into the cutting-edge science of hemorheology or blood fluidity.
The "No Pressure" Solution
Dr. David Derose
High Blood Pressure. Even if you haven’t received the diagnosis yet, as many as three-quarters of the Western world will have to contend with high blood pressure sometime in their lives.
Clean Skin from Within
Trevor Cates
If you have a common skin condition, such as acne, rosacea, eczema, or psoriasis, or are just looking to give your skin a boost, you can skip the trip to your dermatologist.
Head First
David Tomen
Nootropic supplements can help increase your memory, boost learning ability, improve your mood, decrease depression, tame anxiety, and even help you think faster.
Why We Age
David Sinclair PhD
A resource book about the logarithmic in Sciences & Technologies, New Quantum Physics, Quantum Biology- a must-have for those that want to improve their health.
Exercise and the Brain
John J. Ratey, MD
A groundbreaking and fascinating investigation into the transformative effects of exercise on the brain, from the bestselling author and renowned psychiatrist John J. Ratey, MD.
I Contain Multitudes
Ed Young
Joining the ranks of popular science classics like The Botany of Desire and The Selfish Gene, a groundbreaking, wondrously informative, and vastly entertaining examination of the most significant revolution in biology since Darwin
The Hormone Solution
Thierry Hertoghe, M.D.
America’s perceptions about the inevitable effects of aging are about to be completely rethought, thanks to groundbreaking new information from an internationally known expert on hormones and antiaging medicine.
Testosterone
Thierry Hertoghe, M.D.
Testosterone, the therapy for real gentlemen is an innovative book, based on Dr. Hertoghe’s vast experience that gives practical advice to physicians about what they need to know about testosterone to administer it to men.
Passion, Sex, and Long Life
Thierry Hertoghe, M.D.
This general public book on possibly one of the most important hormones in humans explains why many people may need to take a supplement of oxytocin the hormone not only of orgasm, but also of tender love, attachment, friendliness, and passion.